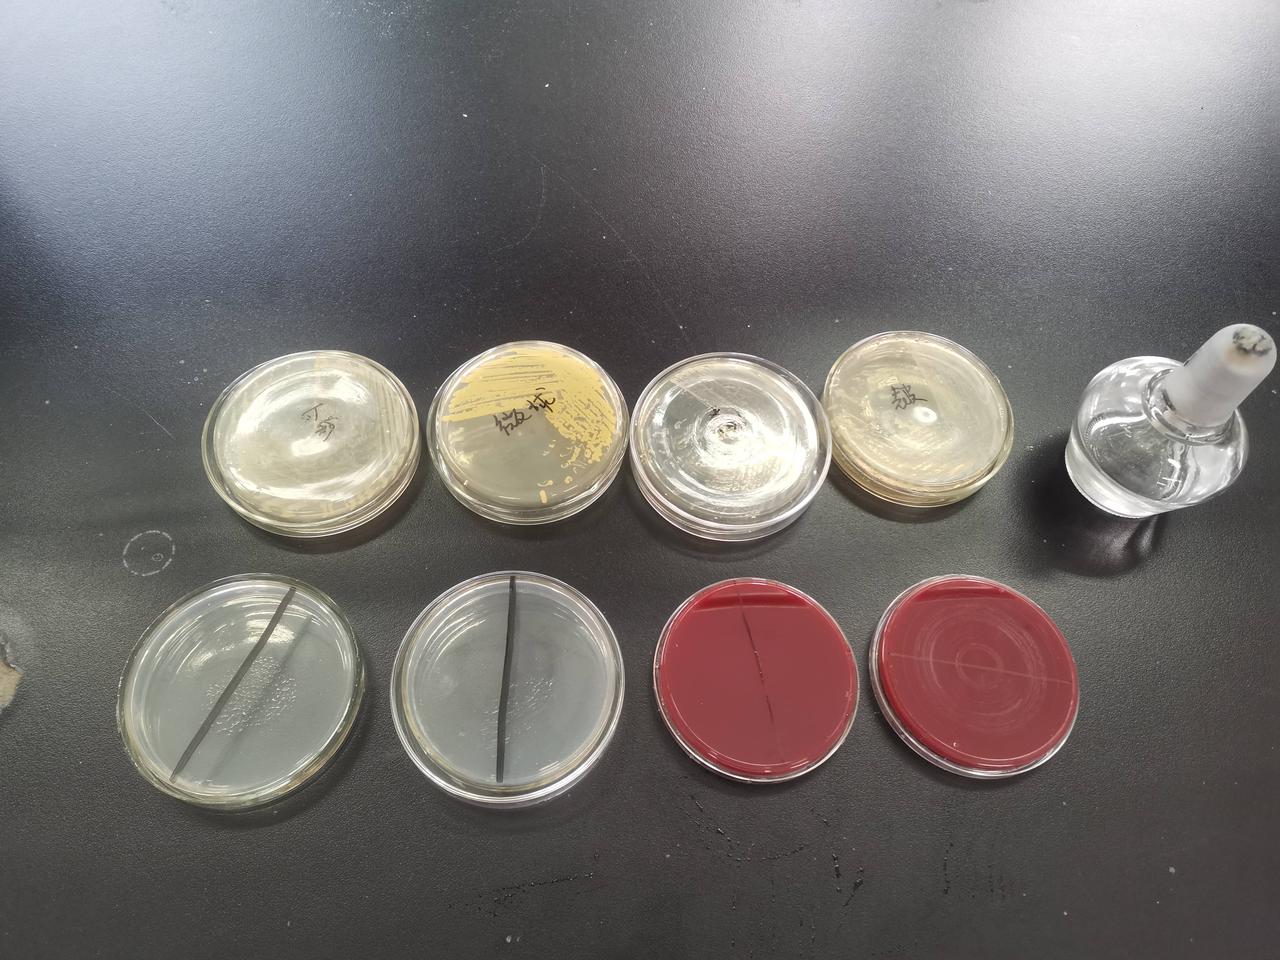
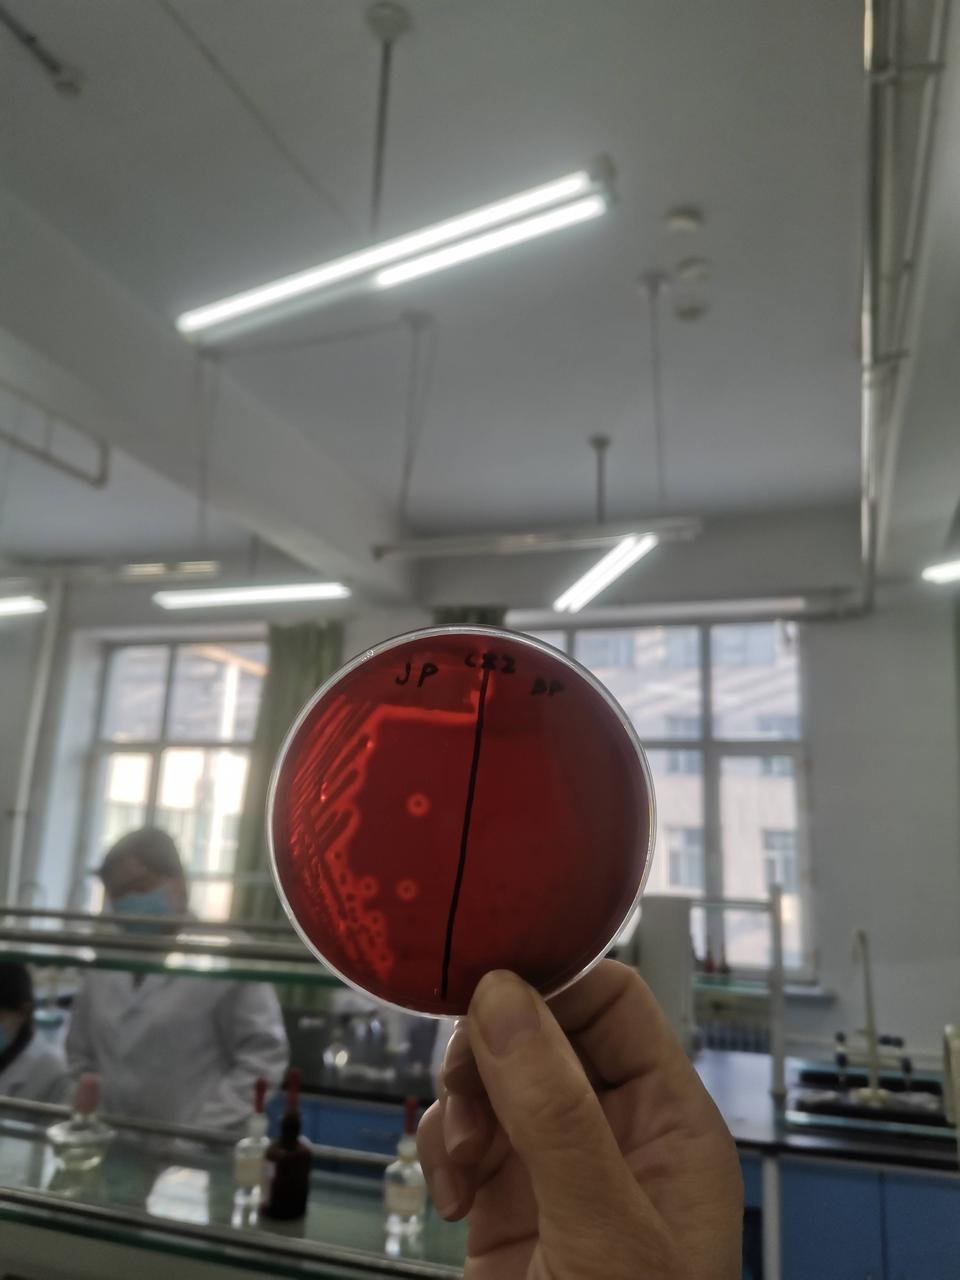
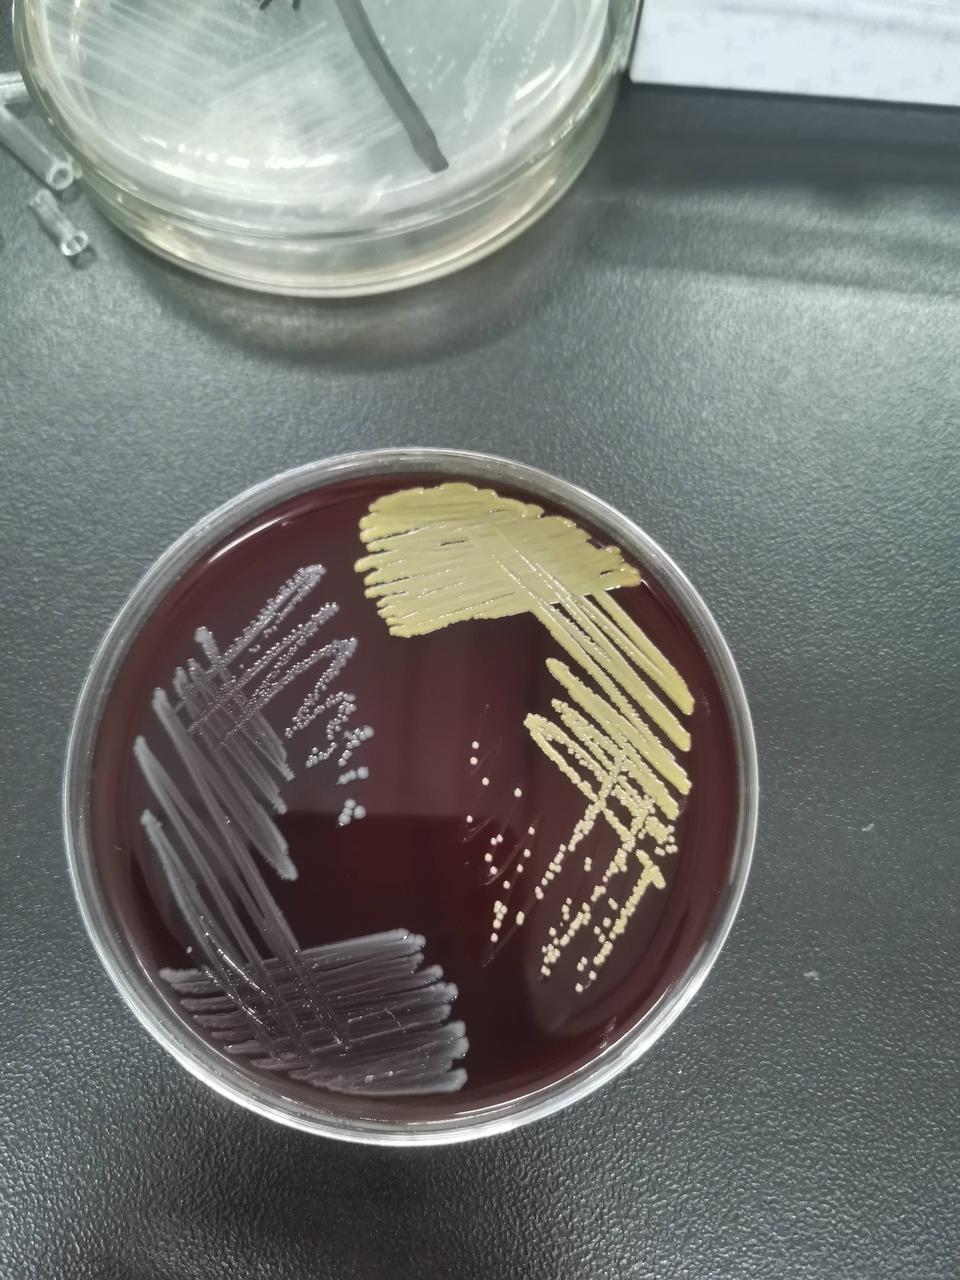
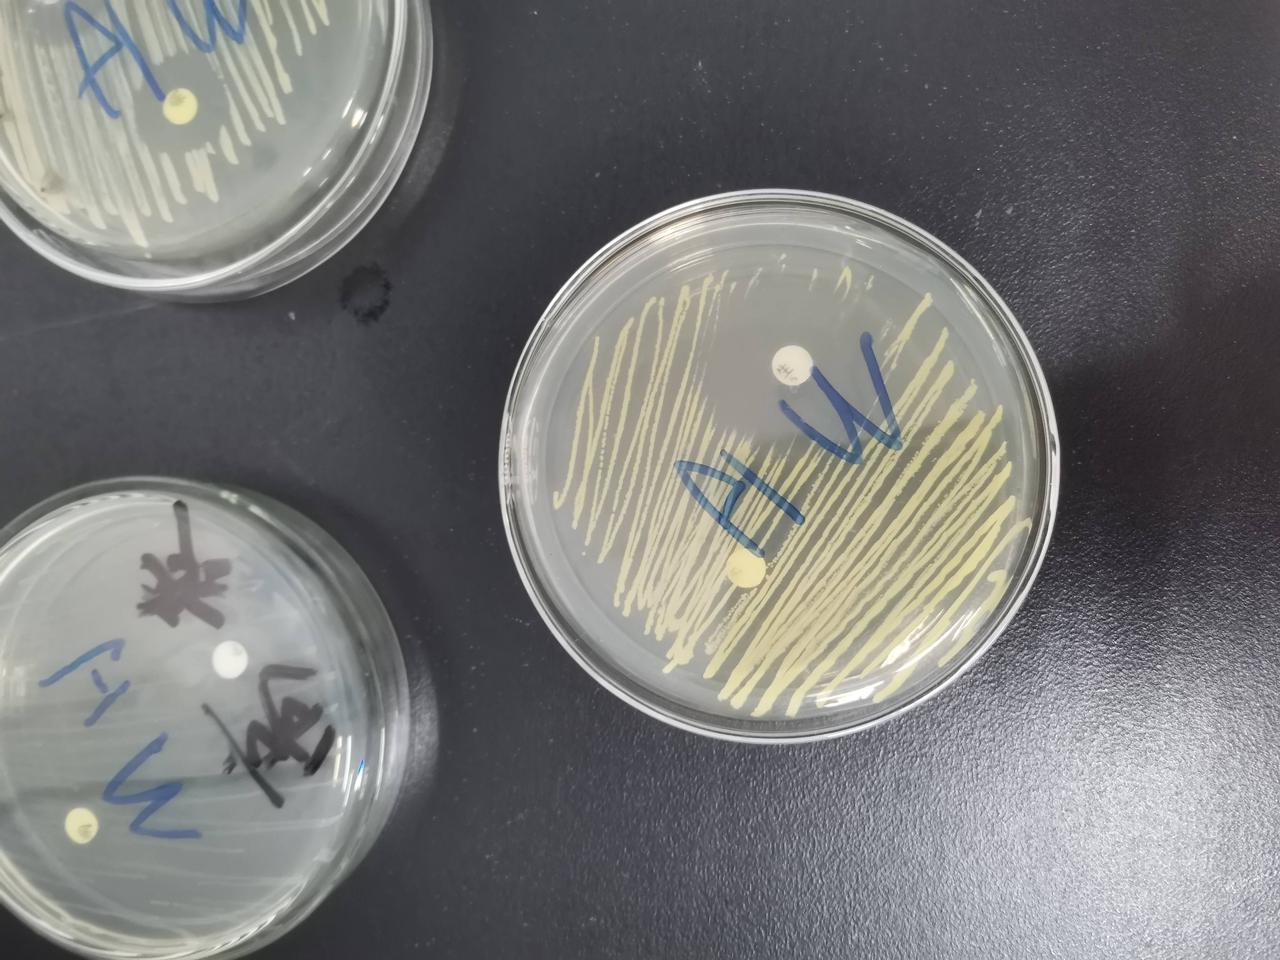
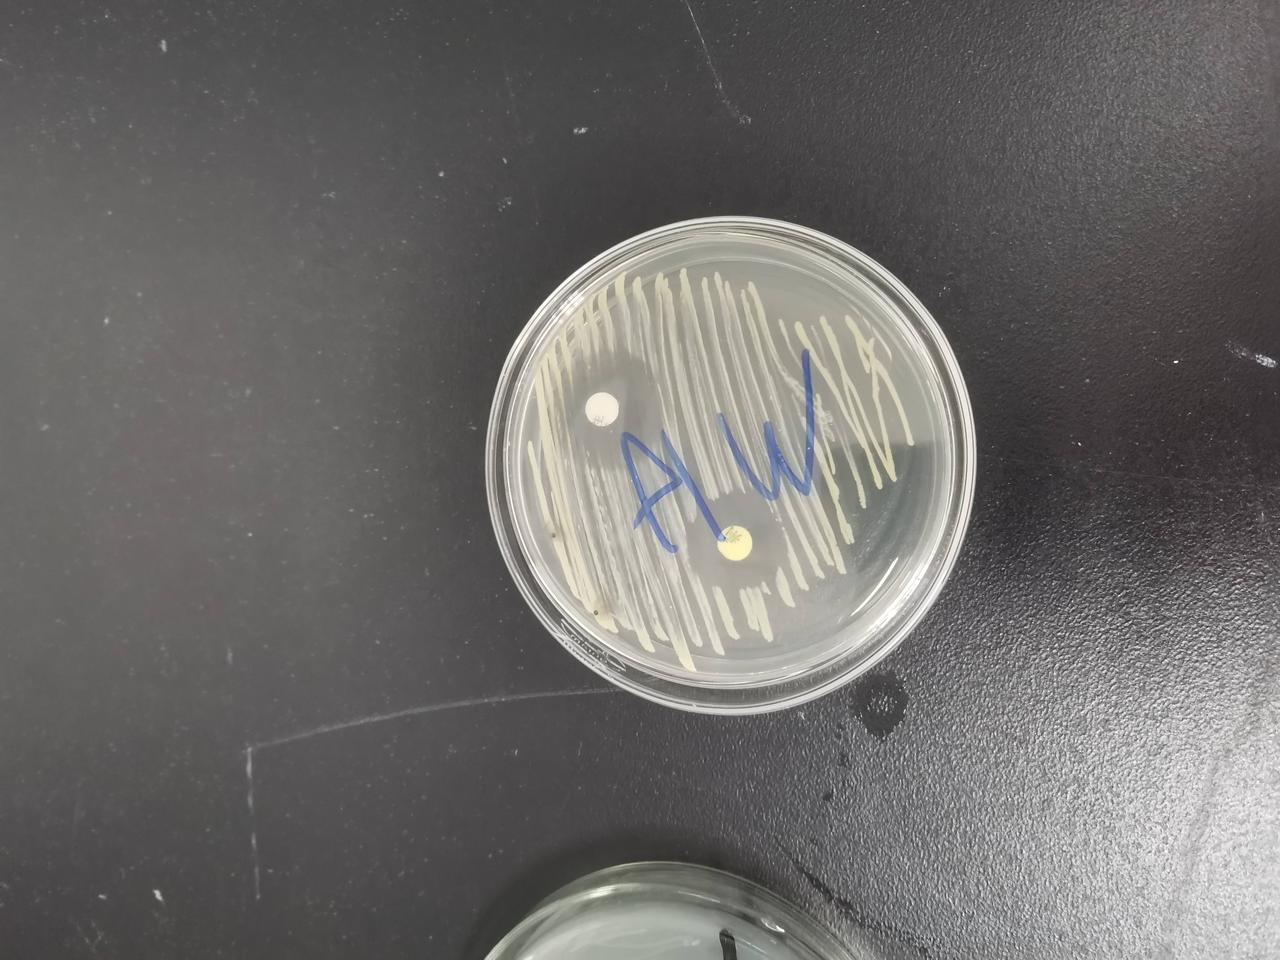

球菌的鉴定
上一节
下一节
1.分离培养


生化反应
1.触酶试验
2.血浆凝固酶试验(玻片法)
3.新生霉素敏感实验和呋喃唑酮敏感试验


目录
1.分离培养

生化反应
1.触酶试验
2.血浆凝固酶试验(玻片法)
3.新生霉素敏感实验和呋喃唑酮敏感试验